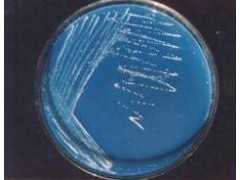

Product detail:
A. Effects
Use multistrains- multifunctional biofertilizer Azotobacterin will help to create the safe and high quality agricultural products, increase income for farmers and protect ecological environment because of the following effects:
1. Create bionitrogenous fertilizer and nutrition for plants, therefore help to reduce 50% to 100% content of urea or 50% to 100% content of NPK ( nitrogen- phosphorus- kalium) compare with formula on a large scale according to little or much of fertilizer content used.
2. Multistrains- Multifunctional biofertilizer Azotobacterin has the effect to promote plant growth, therefore increase plant yield from 15% to 30% or higher according to little or much of fertilizer content used
3. Help the plants have resistant ability for pests, therefore reduces toxic chemical pesticides, create safe agricultural products and protect ecological environment.
4. Reduce toxic nitrate content in agricultural products, create safe agricultural products.
5. Increase nutritive content in agricultural products such as protein, vitamin, therefore have effect to increase quality of agricultural products, help agricultural products to have better taste compare with fertilizing by chemical fertilizer.
6. Has the effect to rapidly degrade rice straw into organic humus only after 7 days directly in the field, therefore help reduce organic poisoning for rice plant and reduce environmental pollution.
7. Improve soil, help soil to become soft, reduce alum poisoning, organic poisoning in the soil, increase the ability of damp keeping of the soil , and reduce wild grass in the soil.
B. Dosage
- For rice plant:
+ Fertilize 10 kg for 360 m2, reduce 50% chemical fertilizer NPK of large scale formula.
- For vegetable and crops:
+ Fertilizer from 10 kg to 15 kg for 360 m2, reduce from 30% to 50% of chemical fertilizer NPK of large scale formula
- For fruit plant:
+ Fertilizer from 1 kg to 2 kg or more for one plant according to big or small plant
- For flower
+ Fertilize from 0, 1 kg to 0,3 kg for one plant according to big or small plant
- For industrial trees (coffee, pepper): Fertilize from 0,5 to 0,6 kg for one tree.
- For tee tree
+ Fertilize from 30 to 50 kg for 360 m2, according to thin or dense of plant density, reduce 100% urea or 100% NPK fertilizer of large scale formula.
C. Use
You can fertilizer in sheeting or prompting (you should fertilize as soon as possible)
When use ,dissolve fertilizer Azotobacterin with water or soil and to dust to plants.
Attention:
Treatment pH of the soil before fertilize by lime in the sour field
D Storage
Storage in cool place